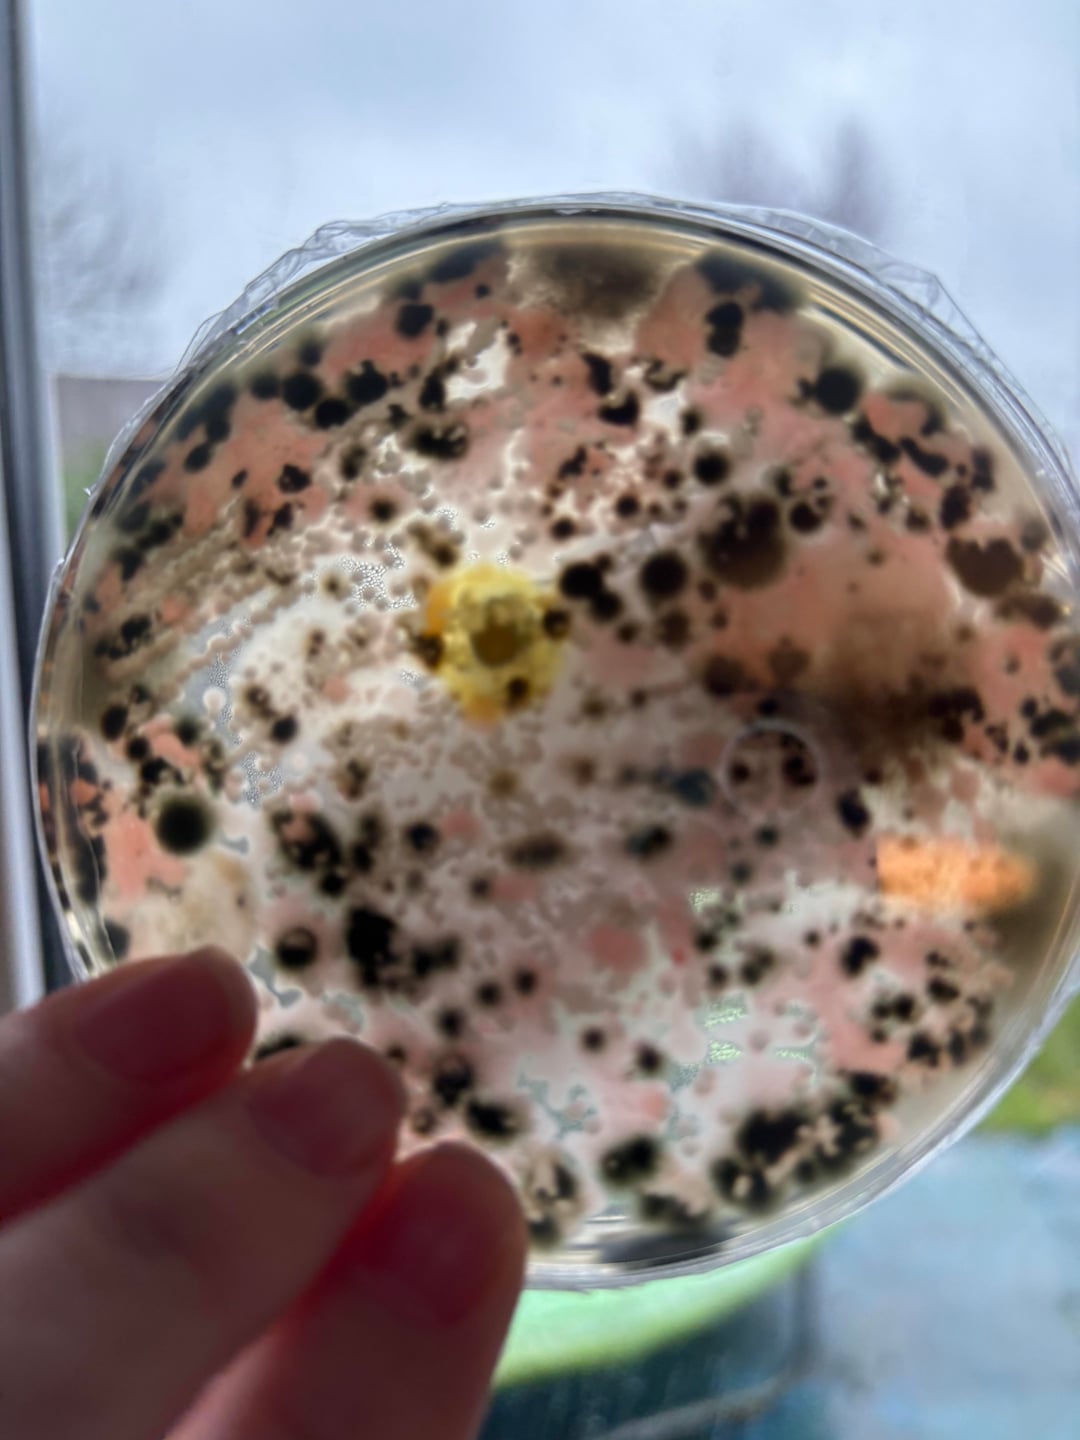
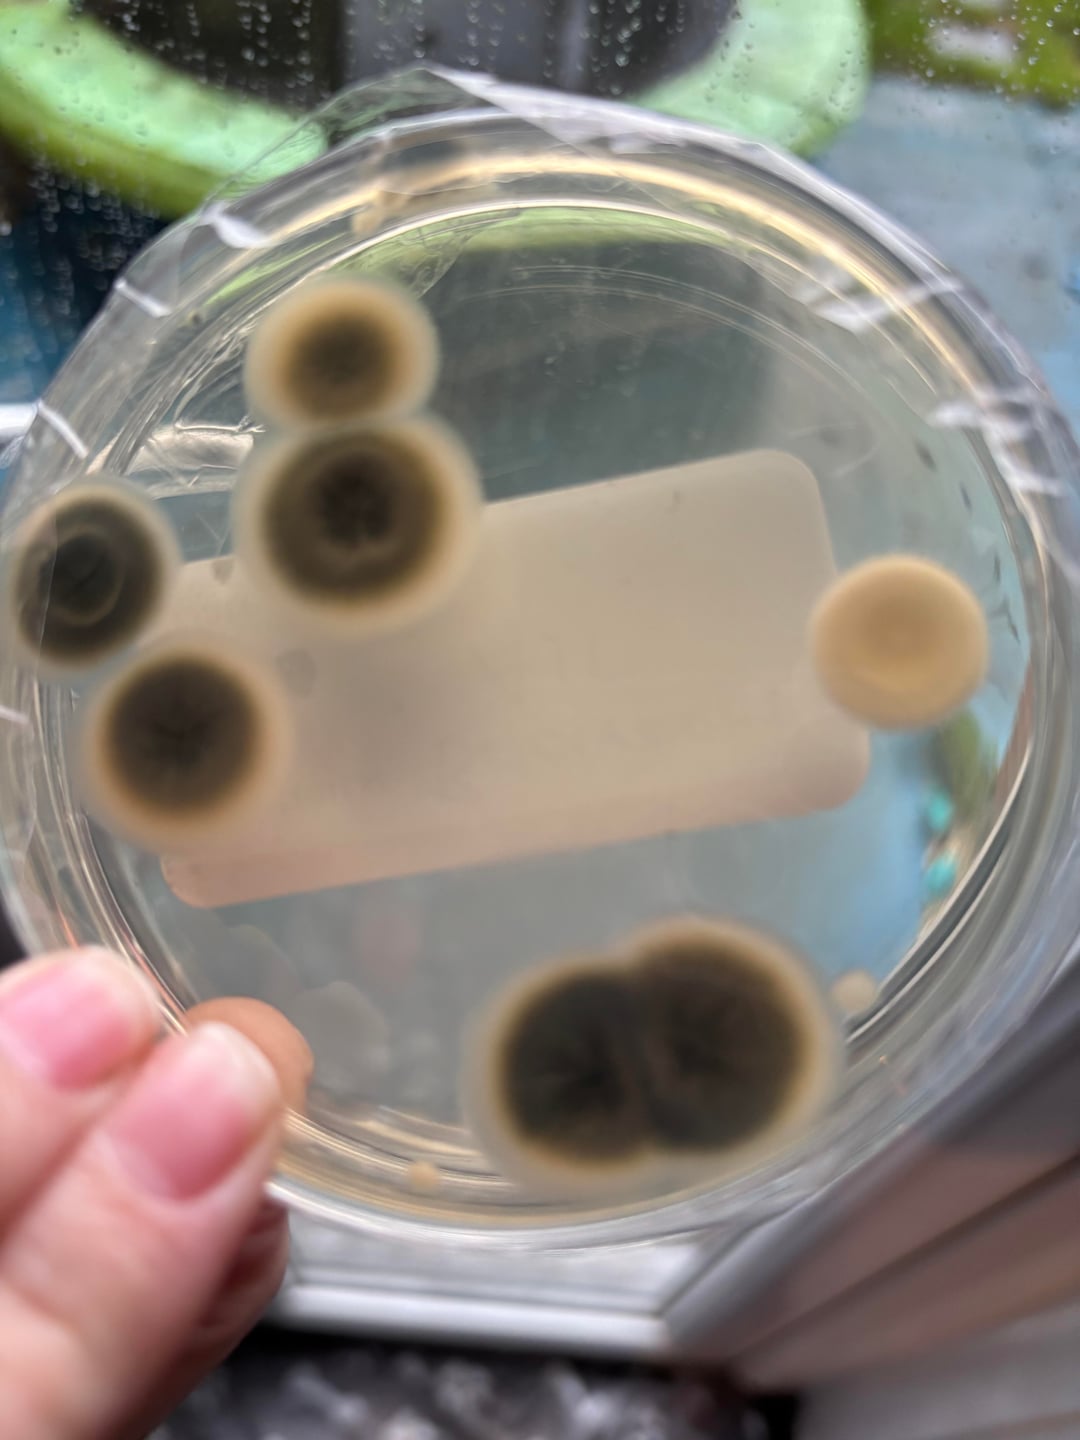
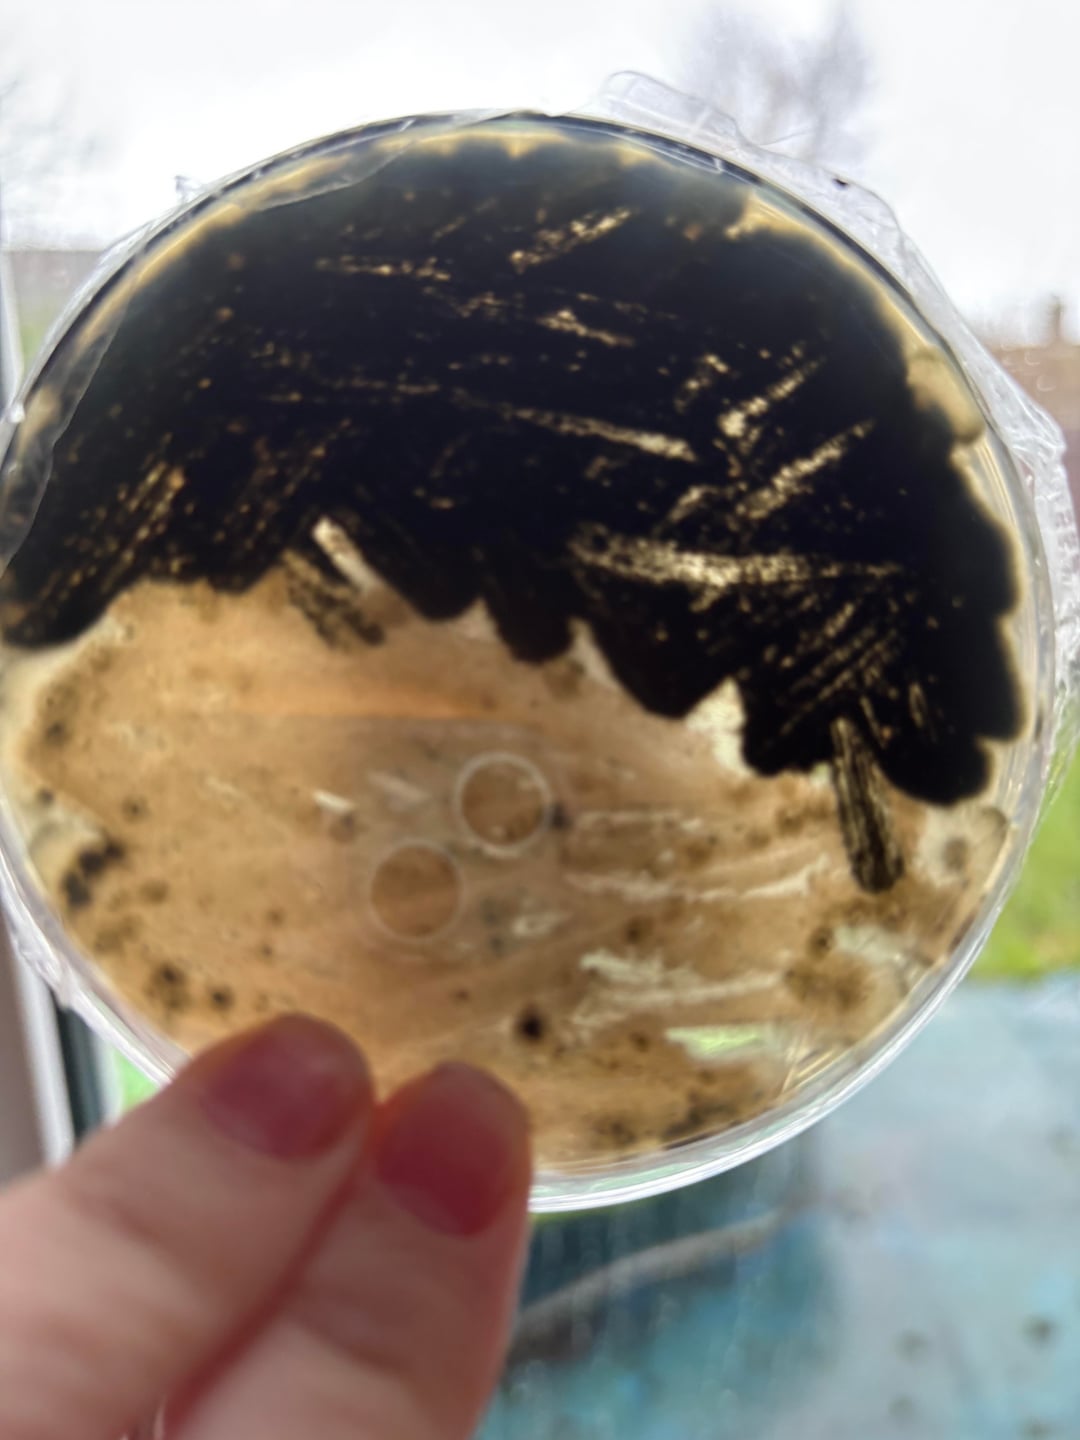
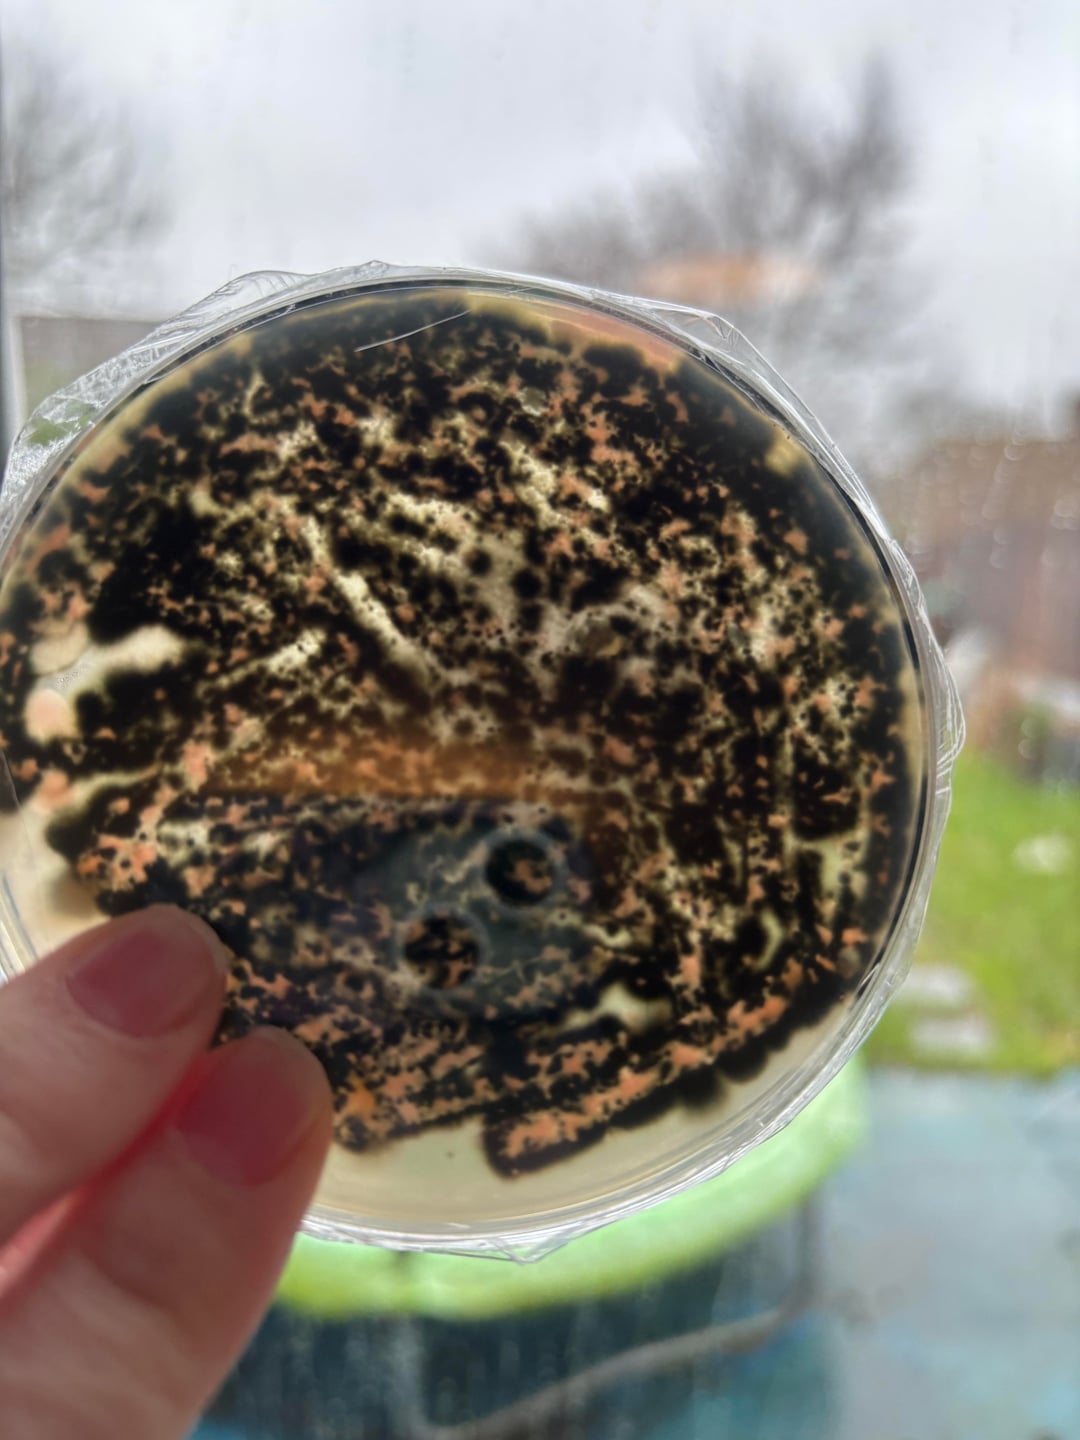
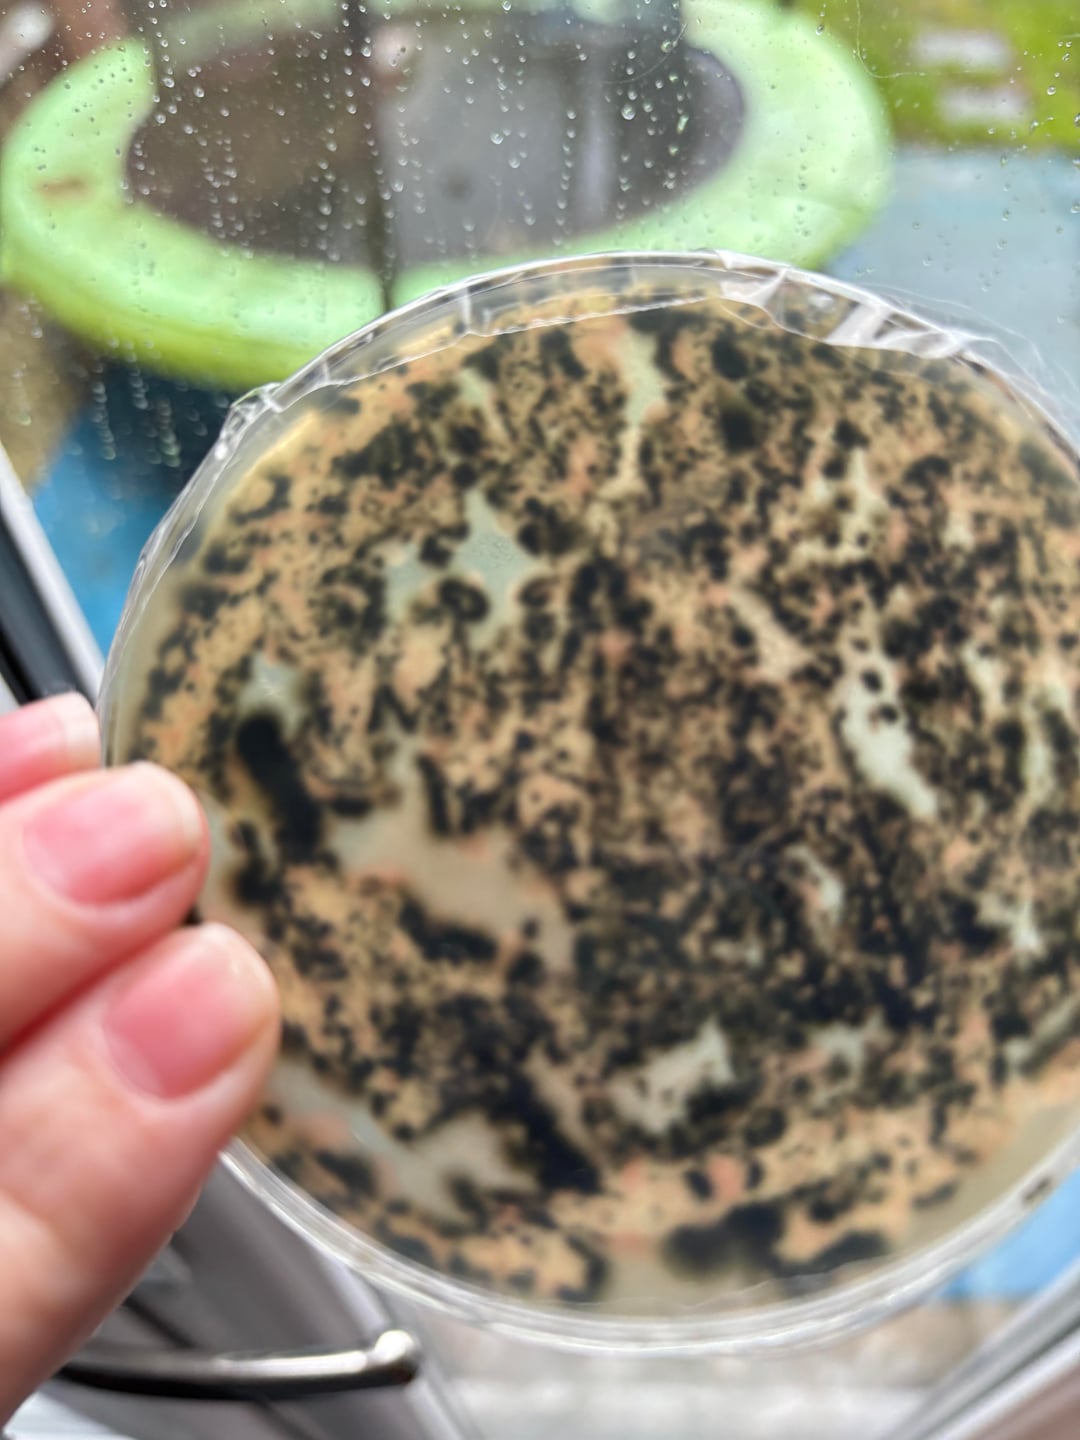
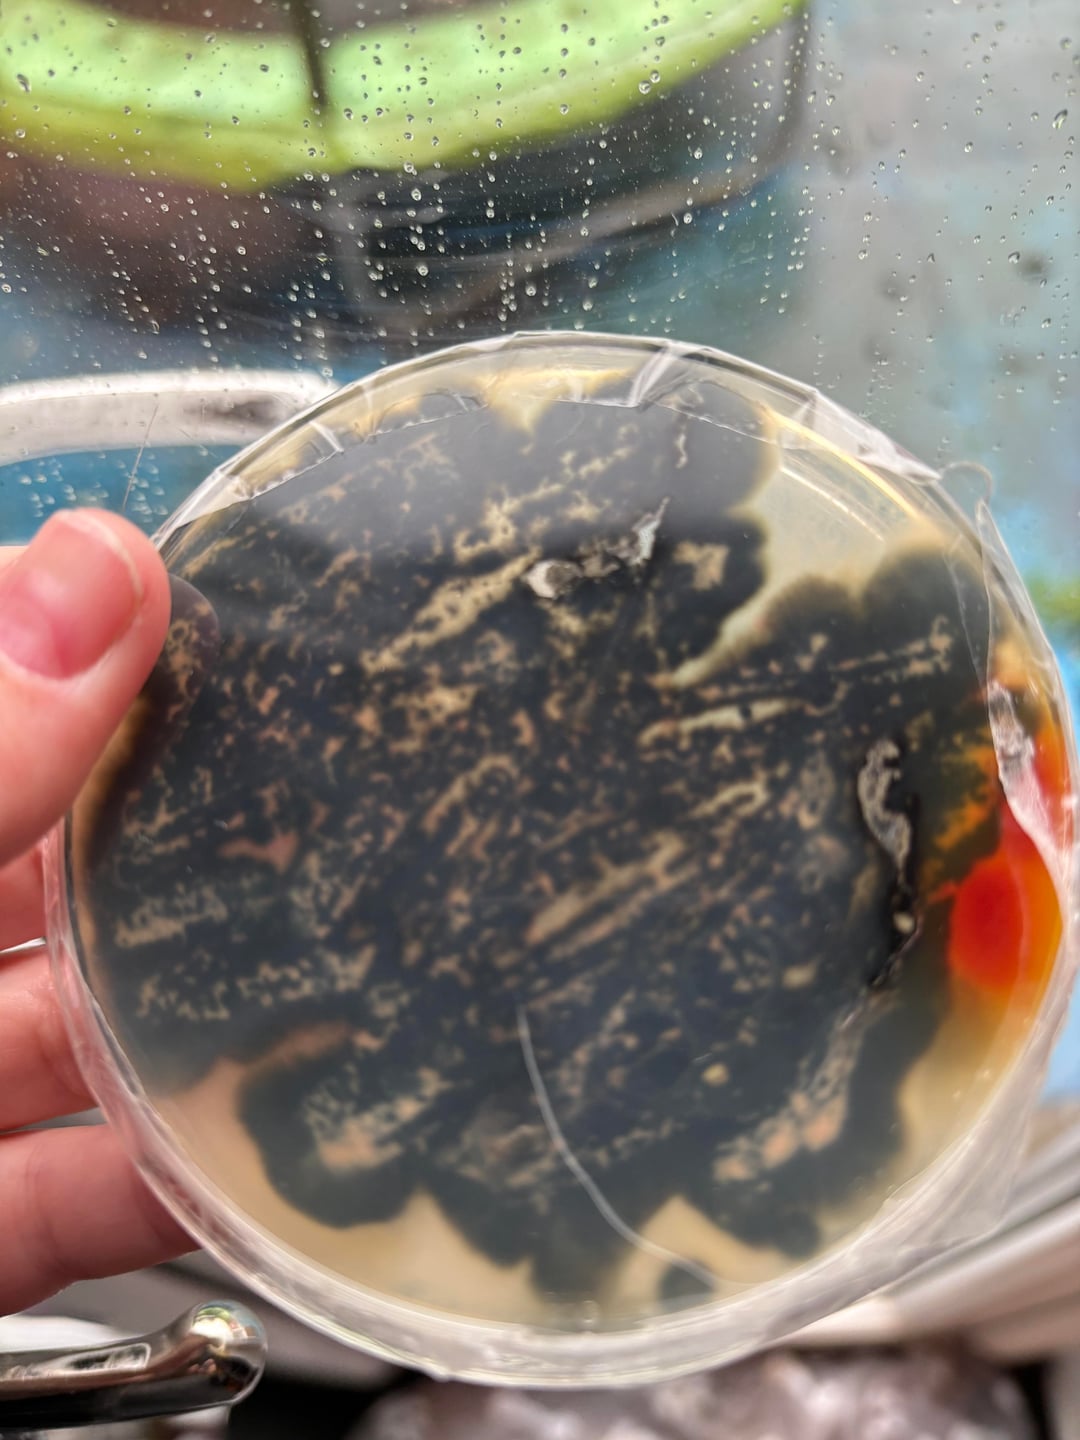

Ich bin ein lebhafter Mieter und sie haben mich jahrelang unter Druck gesetzt und immer noch nichts dagegen unternommen. Seit ich hier lebe, hat sich meine Gesundheit verschlechtert. Bitte helfen Sie mir, den Schimmel zu identifizieren.
https://www.reddit.com/gallery/1rwxvlu

1 Kommentar
Well… it’s certainly black in color…